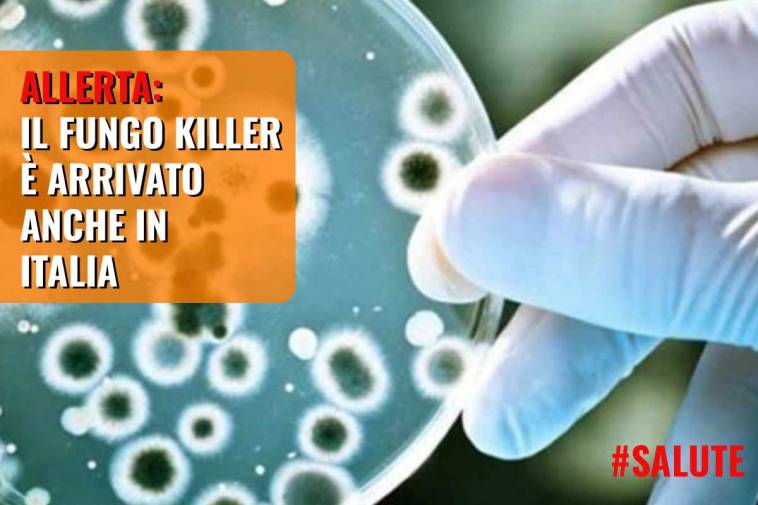

Avreste mai potuto immaginare che la trama di The Last of Us diventasse realtà? Un fungo killer è in agguato
Prima di parlarvi del problema che sta iniziando a preoccupare seriamente la popolazione mondiale, scorrendo su TikTok e alcuni Reels di Instagram notiamo che i giocatori più attenti stanno paragonando il nuovo fungo (di cui vi parleremo nel prossimo paragrafo) con l’epidemia che abbiamo visto in The Last of Us; uno dei videogiochi migliori usciti sul mercato e per molte persone il migliore di sempre.
Il capolavoro firmato Naughty Dog ha avuto un successo strepitoso, non solo per il gameplay, ma anche e soprattutto per trama e personaggi.
Il successo strepitoso del primo capitolo, uscito ormai nel lontano 2013, ha portato allo sviluppo di una seconda parte pubblicata nel 2020 e soprattutto di una serie televisiva targata HBO in programma da gennaio a marzo 2023.
Un vero e proprio fenomeno mondiale che si sta trasformando, purtroppo, anche in realtà.
Senza andare troppo nel dettaglio della trama dell’opera, sappiate che essa si basa sulla proliferazione di un fungo parassita, il Cordyceps, che attacca gli esseri viventi e li trasforma in zombie.
Questa specie di fungo esiste nella realtà e parassita alcuni insetti, ma se esistesse davvero un fungo che attacca gli umani? Purtroppo è la realtà dei fatti, anche se non ci può trasformare in zombie, per fortuna.
Fungo killer in rapida diffusione: è allarme serio in tutto il mondo
Non si tratta di una simulazione o di un’opera a realtà aumentata, ma di un vero proprio fungo killer che sta proliferando in alcuni paesi del mondo.
Proprio come accade nel videogioco di Naughty Dog, anche questo esemplare si sta diffondendo velocemente e sta colpendo gli esseri umani, talvolta uccidendoli.
Si tratta di un fungo che era già presente sul nostro pianeta da parecchi anni, ma che ha iniziato a proliferare in maniera massiccia tra il 2019 e il 2021.
Gli scienziati hanno individuato le cause della proliferazione nella pandemia da Covid-19: durante quel periodo, infatti, le infezioni sono aumentate del 95%.

Il fungo killer è stato segnalato per la prima volta negli Stati Uniti nel 2016 e a causa della sua pericolosità è stato categorizzato come “minaccia urgente”.
Questo non solo perché si diffonde velocemente e facilmente, soprattutto all’interno di strutture sanitarie, ma anche perché incredibilmente resiste alla maggior parte degli antibiotici in circolazione.
Scoperto anche in Italia: non siamo più al sicuro
Il suo nome è Candida auris e il suo nome nasce dal fatto che per la prima volta è stato scoperto nel 2009 nell’orecchio di una paziente.
Nella sua forma invasiva questo fungo killer può infettare il sangue, il sistema nervoso centrale, reni, fegato, ossa, muscoli, articolazioni, milza e anche gli occhi.
Causa infezioni davvero gravi con un alto tasso di mortalità.
Per questo motivo l’OMS, l’Organizzazione Mondiale per la Sanità, ha inserito il Candida auris nella categoria dei funghi patogeni a priorità critica.
Le strutture sanitarie di tutto il mondo non erano minimamente preparate a questo boom di contagi che, secondo gli esperti, è stato causato dalle criticità dovute alla pandemia, come la mancanza di personale e la grande affluenza di pazienti.

Come abbiamo detto in precedenza, il boom di contagi è stato rivelato negli Stati Uniti, in particolare in circa la metà degli stati del paese.
Nonostante si stia diffondendo a macchia d’olio nei paesi del Nord America, come ad esempio anche il Canada, è stata rivelata la sua presenza anche in altre parti del mondo, compresa l’Italia.
Un caso è stato isolato in Toscana, precisamente a Pisa, dove un uomo originario di La Spezia è stato ricoverato nel reparto di malattie infettive.
Secondo gli esperti i sintomi da infezione da Candida auris sono dolori muscolari, difficoltà a deglutire, affaticamento, febbre e bruciori; in alcuni casi però l’infezione potrebbe essere completamente asintomatica.
Fonte: Reuters / Skytg 24 / ISS